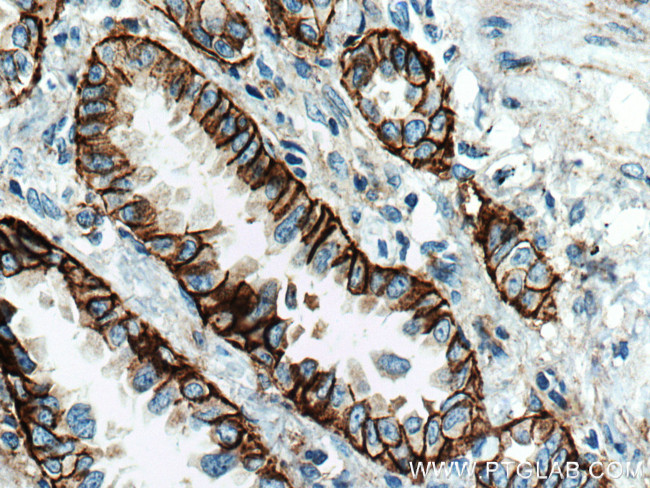
Integrin alpha-3 Antibody in Immunohistochemistry (Paraffin) (IHC (P))

Search
Proteintech
Integrin alpha-3 Monoclonal Antibody (3F9G4)
{{$productOrderCtrl.translations['antibody.pdp.commerceCard.promotion.promotions']}}
{{$productOrderCtrl.translations['antibody.pdp.commerceCard.promotion.viewpromo']}}
{{$productOrderCtrl.translations['antibody.pdp.commerceCard.promotion.promocode']}}: {{promo.promoCode}} {{promo.promoTitle}} {{promo.promoDescription}}. {{$productOrderCtrl.translations['antibody.pdp.commerceCard.promotion.learnmore']}}
产品信息
66070-1-IG
种属反应
已发表种属
宿主/亚型
分类
类型
克隆号
抗原
偶联物
形式
浓度
规格
纯化类型
保存液
内含物
保存条件
运输条件
产品详细信息
This antibody can recognize the heavy chain.
Immunogen sequence: FGYSVALHR QTERQQRYLL LAGAPRELAV PDGYTNRTGA VYLCPLTAHK DDCERMNITV KNDPGHHIIE DMWLGVTVAS QGPAGRVLVC AHRYTQVLWS GSEDQRRMVG KCYVRGNDLE LDSSDDWQTY HNEMCNSNTD YLETGMCQLG TSGGFTQNTV YFGAPGAYNW KGNSYMIQRK EWDLSEYSYK DPEDQGNLYI GYTMQVGSFI LHPKNITIVT GAPRHRHMGA VFLLSQEAGG DLRRRQVLEG SQVGAYFGSA IALADLNNDG WQDLLVGAPY YFERKEEVGG AIYVFMNQAG TSFPAHPSLL LHGPSGSAFG LSVASI (52-376 aa encoded by BC150190)
靶标信息
ITGA3 (INTEGRIN, ALPHA-3), also called CD49C, VLA3 or GAPB3, is a protein that in humans is encoded by the ITGA3 gene. ITGA3 is an integrin alpha subunit which is also a member of the family of cell surface adhesion molecules. ITGA3 is mapped to chromosome 17 and its exact cytogenetic location is 17q21.33. ITGA3 makes up half of the alpha3beta1 integrin duplex that plays a role in neural migration and corticogenesis together with beta-1 subunit. A functional link between DAB1 phosphorylation and ITGA3 signaling drives the timely detachment of migrating neurons from radial glial fibers. Expression of human ITGA3 increased the infectivity of virus for Chinese hamster ovary cells. ITGA3 also contains 13 potential N-glycosylation sites, 2 potential cleavage sites, and the 7 N-terminal repeating units characteristic of ITGAs. Recombinant ITGA3 is expressed as a 150-kD protein as the same size as the native protein by the western blot analysis.
仅用于科研。不用于诊断过程。未经明确授权不得转售。
生物信息学
蛋白别名: alpha 3 subunit of VLA-3 receptor; Alpha3 integrin; antigen CD49C; antigen identified by monoclonal antibody J143; CD49 antigen-like family member C; CD49c; CD49c antigen; FLJ34631; FLJ34704; FRP-2; Galactoprotein B3; GAPB3; integrin alpha 3; Integrin alpha-3; Integrin alpha3; integrin, alpha 3 (antigen CD49C, alpha 3 subunit of VLA-3 receptor); testicular tissue protein Li 96; testicular tissue protein Li 98; unnamed protein product; very late activation protein 3 receptor, alpha-3 subunit; very late activation receptor subunit alpha-3; VLA-3 subunit alpha
基因别名: AA407068; CD49C; FRP-2; GAP-B3; GAPB3; ILNEB; ITGA3; JEB7; MSK18; VCA-2; VL3A; VLA3a
UniProt ID: (Human) P26006, (Mouse) Q62470
Entrez Gene ID: (Human) 3675, (Pig) 100517053, (Mouse) 16400